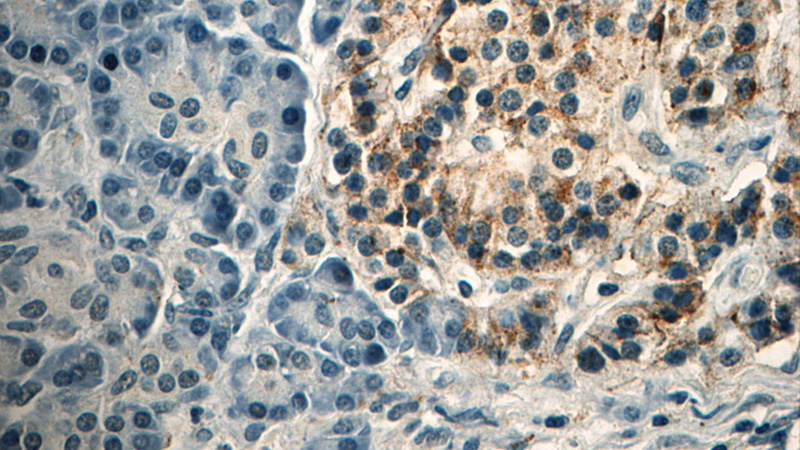
Immunohistochemistry of paraffin-embedded human pancreas tissue slide using Catalog No:107034(Caspase 9 Antibody) at dilution of 1:50 (under 40x lens)

-
Product Name
Caspase 9/p35/p10 antibody
- Documents
-
Description
Caspase 9/p35/p10 Mouse Monoclonal antibody. Positive IHC detected in human pancreas tissue. Positive IP detected in HeLa cells. Positive WB detected in HeLa cells. Observed molecular weight by Western-blot: 46 kDa,36 kDa
-
Tested applications
ELISA, WB, IHC, IP
-
Species reactivity
Human, Mouse; other species not tested.
-
Alternative names
APAF 3 antibody; APAF3 antibody; Apoptotic protease Mch 6 antibody; CASP 9 antibody; CASP9 antibody; Caspase 9 antibody; Caspase 9/p35/p10 antibody; CASPASE 9c antibody; Caspase9 antibody; Caspase-9 antibody; ICE LAP6 antibody; ICE like apoptotic protease 6 antibody; MCH6 antibody
-
Isotype
Mouse IgG2b
-
Preparation
This antibody was obtained by immunization of Caspase 9/p35/p10 recombinant protein (Accession Number: NM_001229). Purification method: Protein A purified.
-
Clonality
Monoclonal
-
Formulation
PBS with 0.02% sodium azide and 50% glycerol pH 7.3.
-
Storage instructions
Store at -20℃. DO NOT ALIQUOT
-
Applications
Recommended Dilution:
WB: 1:500-1:5000
IP: 1:200-1:2000
IHC: 1:20-1:200
-
Validations

HeLa cells were subjected to SDS PAGE followed by western blot with Catalog No:107034(Caspase 9 Antibody) at dilution of 1:1000

IP Result of anti-Caspase 9 (IP:Catalog No:107034, 5ug; Detection:Catalog No:107034 1:500) with HeLa cells lysate 3200ug.

Immunohistochemistry of paraffin-embedded human pancreas tissue slide using Catalog No:107034(Caspase 9 Antibody) at dilution of 1:50 (under 10x lens)
Immunohistochemistry of paraffin-embedded human pancreas tissue slide using Catalog No:107034(Caspase 9 Antibody) at dilution of 1:50 (under 40x lens)
-
Background
Caspase 9, apoptosis-related cysteine protease (CASP9,synonyms: MCH6, APAF3, APAF-3, ICE-LAP6, CASPASE-9c)is a member of the cysteine-aspartic acid protease (caspase) family. Sequential activation of caspases plays a central role in the execution-phase of cell apoptosis. Caspases exist as inactive proenzymes which undergo proteolytic processing at conserved aspartic residues to produce 2 subunits, large and small, that dimerize to form the active enzyme. Capase 9 is processed by caspase APAF1; this step is thought to be one of the earliest in the caspase activation cascade.
-
References
- Hu L, Su C, Song X. Tetrachlorobenzoquinone triggers the cleavage of Bid and promotes the cross-talk of extrinsic and intrinsic apoptotic signalings in pheochromocytoma (PC) 12 cells. Neurotoxicology. 49:149-57. 2015.
- Chen J, Wang C, Lan W. Gliotoxin Inhibits Proliferation and Induces Apoptosis in Colorectal Cancer Cells. Marine drugs. 13(10):6259-73. 2015.
Related Products / Services
Please note: All products are "FOR RESEARCH USE ONLY AND ARE NOT INTENDED FOR DIAGNOSTIC OR THERAPEUTIC USE"
